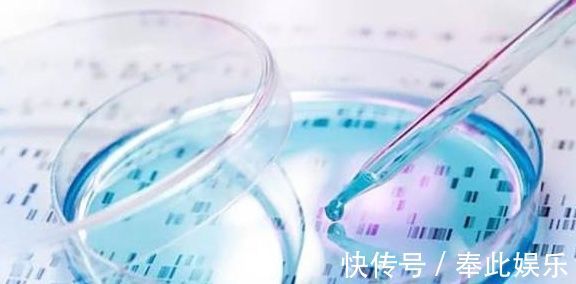
医生|怀孕8个月，老婆就生下了宝宝，丈夫：这是亲生的？

医生|怀孕8个月,老婆就生下了宝宝,丈夫:这是亲生的?
刚生完孩子的小悦迎来了两个烦恼,一是因为自己生孩子的时候有产道撕裂的情况,因此产后恢复起来也会经历不少的疼痛,身体也非常虚弱;而第二个烦恼则是她的丈夫自从自己从产房出来开始表情就非常微妙,似乎是想了很久才在宝宝出生的当天晚上向小悦询问道:这孩子到底是谁的。这个问题气得小悦话都说不清楚,直掉眼泪,骂了丈夫很久,还惊动了当天值夜班的医生和护士。

文章插图
第二天,主管小悦的医生就抽空和小悦夫妇聊了一会儿。在小悦的丈夫看来怀胎十月天经地义,可是小悦生孩子和其他的产妇不太一样,才怀孕8个多月分娩了。虽然医生说宝宝的状况还不错,但是他总觉得心里有点不舒服,因此宝宝出生的时候也没有表现得太开心。反复想了很久才选择在晚上没有亲友探望时直接询问了小悦,可是没有想到小悦对这件事这么生气。

文章插图
其实这种丈夫因为妻子分娩的时期与预产期有差距而出现争执的情况,医生遇到过不少,于是医生也开始耐心的为小悦丈夫解释这类情况发生的原因。虽然大家总爱说“怀胎十月”,但是从医学的角度准确的说应该是“妊娠四十周”,总的算下来有280天。之所以会这么算是因为孕期的开始应该是从受精卵形成开始算起,但是要获得这一准确的时间比较困难。因此医生会从女性孕前最后一次月经首日开始推算预产期,这也可以看出预产期并不是完全准确的数字,只能说是大致的期限。

文章插图
像小悦这样怀孕八个多月生产的情况也是存在的,有可能是预产期的计算上有些许误差。因为仔细想一下预产期从经期首日开始推算,但是在此之后大家还会经历好几天的月经来潮,还得等待排卵,这其中肯定会产生误差的。倘若丈夫对妻子仍然没有信任感,终究放心不下孩子到底是谁的骨肉,也可以运用亲子鉴定的方法直接检查血缘关系。听到医生的解释之后小悦的丈夫也理解了妻子为什么怀孕8个多月就会生孩子,当妻子建议自己做亲子鉴定时,小悦的丈夫也果断拒绝了,经过调解夫妻之间的矛盾也得到了解决。

文章插图
其实像小悦丈夫这样因为长期以来的认知被打破而产生的怀疑还是可以原谅的,但是也有一些丈夫为了安心选择了采用亲子鉴定来确认血缘关系。这种行为对夫妻关系、亲子关系的伤害也是很大的,鉴定之后很多夫妇关系也由此破灭了。倘若夫妇之间还存在着信任,就没有必要采取这种方式。
文章插图
【 医生|怀孕8个月,老婆就生下了宝宝,丈夫:这是亲生的?】或许是因为“十月怀胎”这个观念已经深入人们的脑海之中,因此仍然有很多人认为女性的孕期有十个月。与医生交流过大家也会明白,其实预产期提前一段时间生孩子也是很正常的,通常在2-3周之内都不用担心早产,孩子很有可能也是足月生产。
- 思俊外科静脉曲张专科治疗团队是张强医生集团吗 哪里治疗腿部静脉曲张
- 请问你们知道照顾一个瘫痪的老人有多难吗 广州看糖尿病比较好的医生
- 发现自己怀孕了怎么办 少女早孕怎么办
- 上海华山医院王邵华医生评价怎么样 上海华山医院肢体重建
- 八个月宝宝发烧吃什么药 8个月的宝宝发烧38.5怎么办
- 14岁女孩身高直冲175厘米,儿科医生:3样食物是“长高王”,可敞开吃
- 怀孕的征兆有哪些 女人怀孕的14个信号
- 特殊时期:3岁孩子咬破水银体温计,妈妈60秒专业处理 获医生点赞
- 不容易怎么办 怎么才能更容易怀孕
- 为什么有医生给八个月的小孩开方子让舔蜂蜜 蜂蜜小孩几岁才可以吃
特别声明:本站内容均来自网友提供或互联网,仅供参考,请勿用于商业和其他非法用途。如果侵犯了您的权益请与我们联系,我们将在24小时内删除。
